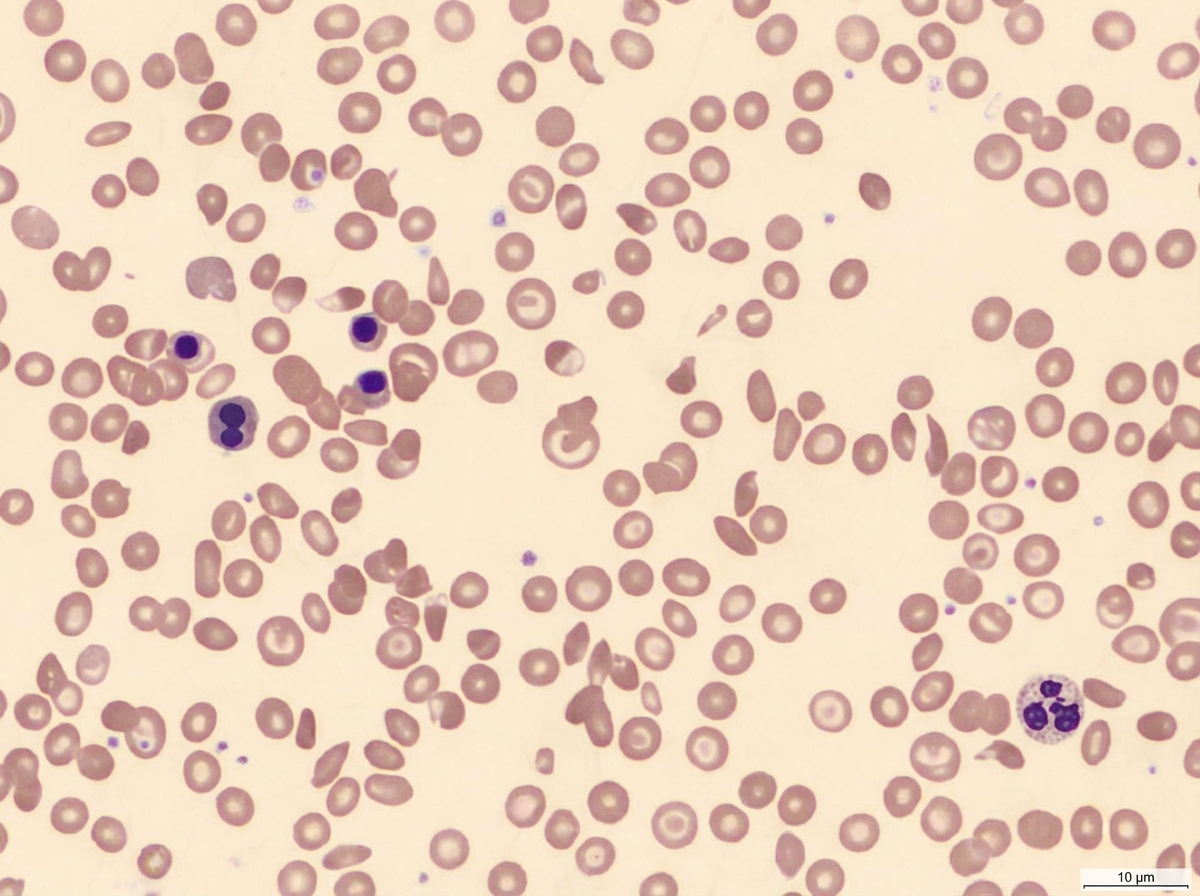
Image for question 741

Spot the diagnosis?
Spur cells are seen in which of the following conditions?
A 48-year-old woman complains of weakness, fatigue, and easy bruisability for 2 months. She had worked as a technician in a nuclear energy plant for 15 years and was involved in an accident during which she was exposed to considerable radiation. Physical examination reveals an enlarged liver and spleen. What disease is the likely cause of her condition?
What is the reason for hydrops fetalis in Hb Barts disease?
A patient presents with Hb level 6 g/dL, TLC 3500/mm 3, and platelet count 50,000/mm 3. What is the most probable diagnosis?
A 50-year-old man presents with fever and diffuse lymphadenopathy. A lymph node biopsy reveals non-Hodgkin follicular lymphoma. Immunohistochemical staining of neoplastic lymphoid cells within the nodular areas of the lymph node would be expected to stain positively for which of the following protein markers?
HbE is common in which region of India?
The most striking haematological finding in agranulocytosis is?
Which syndrome is not associated with leukemia?
What is the best screening test for hemophilia?
Explanation: ***Megaloblastic anemia*** - Characterized by **macro-ovalocytes** (large oval-shaped RBCs) and **hypersegmented neutrophils** (>5 nuclear lobes) on peripheral blood smear. - Results from **vitamin B12** or **folate deficiency**, leading to impaired DNA synthesis and abnormal cell morphology. *Thalassemia* - Shows **microcytic hypochromic** RBCs with **target cells** and **teardrop cells** on peripheral smear. - Caused by **globin chain synthesis defects**, not vitamin deficiencies, resulting in smaller cell size. *Dimorphic anemia* - Presents with a **mixed population** of both **microcytic** and **macrocytic** RBCs on the same smear. - Often seen in **combined deficiencies** (iron + B12/folate) or **sideroblastic anemia**, showing dual cell populations. *G6PD deficiency* - Demonstrates **bite cells** and **blister cells** during hemolytic crises triggered by oxidative stress. - **Heinz bodies** may be visible with special stains, representing precipitated hemoglobin within RBCs.
Explanation: **Explanation:** The correct answer is **None of the above** because the options provided list conditions typically associated with **Burr cells (Echinocytes)** rather than **Spur cells (Acanthocytes)**. **1. Understanding the Difference:** * **Spur Cells (Acanthocytes):** These are RBCs with a few irregularly spaced, thorny projections of varying lengths. They result from an imbalance in membrane lipids (increased cholesterol-to-phospholipid ratio). They are classically seen in **Abetalipoproteinemia** and **Severe Liver Disease** (specifically "Spur Cell Anemia" in cirrhosis). * **Burr Cells (Echinocytes):** These are RBCs with multiple, short, blunt, and *uniformly* spaced projections. They are typically seen in **Uremia**, **Gastric Carcinoma**, and **Hepatocellular Carcinoma**. **2. Analysis of Options:** * **Option A (Uremia):** This is the classic association for **Burr cells**. The metabolic changes in renal failure alter the osmotic environment, leading to uniform crenation of the RBC membrane. * **Option B & C (HCC and Gastric Carcinoma):** Microangiopathic changes or metabolic disturbances in these malignancies frequently lead to the formation of **Burr cells**, not spur cells. **3. High-Yield Clinical Pearls for NEET-PG:** * **Mnemonic for Burr Cells:** "**U**nder **G**raduate **H**ematology" (**U**remia, **G**astric Carcinoma, **H**CC/Liver disease). * **Mnemonic for Spur Cells:** "**A**canthocytes = **A**betalipoproteinemia." * **Key Distinction:** Burr cells are often reversible (can revert to normal shape in healthy plasma), whereas Spur cells are irreversible due to permanent membrane remodeling by the spleen.
Explanation: **Explanation:** **1. Why Chronic Myelogenous Leukemia (CML) is correct:** The patient presents with a classic triad of symptoms (fatigue, bruisability), physical findings (hepatosplenomegaly), and a critical environmental risk factor: **ionizing radiation**. Exposure to high doses of radiation is a well-documented risk factor for the development of myeloid leukemias, particularly CML. Massive splenomegaly is a hallmark of CML due to extramedullary hematopoiesis and leukemic infiltration [1], [2]. The age (48 years) also fits the typical peak incidence of CML (40–60 years) [2]. **2. Why the incorrect options are wrong:** * **Hairy cell leukemia:** While it presents with massive splenomegaly, it is not strongly associated with radiation exposure. It typically presents with "dry tap" on bone marrow aspiration and pancytopenia, rather than the hypermetabolic symptoms seen here [2]. * **Metastatic carcinoma (Breast/Stomach):** While these can cause hepatomegaly, they rarely cause massive splenomegaly. Furthermore, the direct link between a specific radiation accident and these solid tumors is less immediate and characteristic than the link to leukemogenesis in this clinical vignette. **3. NEET-PG High-Yield Pearls:** * **Cytogenetics:** CML is defined by the **Philadelphia chromosome t(9;22)**, creating the *BCR-ABL1* fusion gene with constitutive tyrosine kinase activity. * **Clinical Sign:** Massive splenomegaly is most commonly associated with CML, Myelofibrosis, and Malaria/Kala-azar [1]. * **Lab Finding:** Low **Leukocyte Alkaline Phosphatase (LAP) score** is a key differentiator of CML from a leukemoid reaction. * **Drug of Choice:** Imatinib (Tyrosine Kinase Inhibitor). **References:** [1] Cross SS. Underwood's Pathology: A Clinical Approach. 6th ed. Common Clinical Problems From Blood And Bone Marrow Disease, pp. 611-612. [2] Kumar V, Abbas AK, et al.. Robbins and Cotran Pathologic Basis of Disease. 9th ed. Diseases of White Blood Cells, Lymph Nodes, Spleen, and Thymus, pp. 625-626.
Explanation: **Explanation:** **Hb Barts disease** (Alpha-thalassemia major) occurs when all four alpha-globin genes are deleted (--/--). In the absence of alpha chains, the excess gamma ($̴$) chains produced during the fetal period form tetramers ($̴_4$), known as **Hb Barts** [1]. **1. Why Option C is Correct:** The primary pathology is not a lack of oxygen binding, but a failure of delivery. Hb Barts has an **extremely high oxygen affinity** (approximately 10 times higher than HbA). On the oxygen dissociation curve, this represents a massive **leftward shift**. Because Hb Barts binds oxygen so tightly, it fails to release it to fetal tissues, resulting in severe **intrauterine tissue hypoxia**. This leads to high-output cardiac failure, generalized edema (anasarca), and fetal death (Hydrops Fetalis) [1], [2]. **2. Why Incorrect Options are Wrong:** * **Option A:** Hb Barts actually binds oxygen very efficiently; the problem is its inability to dissociate from it. * **Option B:** This describes the mechanism of **Beta-thalassemia major**, where excess alpha chains precipitate (Heinz bodies) [3]. In Alpha-thalassemia, the excess $̴$ or $̲$ chains form soluble tetramers (Hb Barts or HbH) rather than immediate insoluble precipitates. * **Option D:** While microcytosis is present, the hydrops is a hemodynamic and hypoxic consequence, not a mechanical trapping of cells in the placenta. **High-Yield Clinical Pearls for NEET-PG:** * **HbH Disease:** Deletion of 3 alpha genes (--/-̑). Excess $̲$ chains form $̲_4$ tetramers (HbH) [1]. * **Peripheral Smear:** HbH shows a characteristic **"Golf ball appearance"** when stained with Supravital stains (Brilliant Cresyl Blue) due to precipitated $̲$ tetramers. * **Electrophoresis:** Hb Barts is the fastest-moving hemoglobin on alkaline electrophoresis (moves further toward the anode than HbA). **References:** [1] Kumar V, Abbas AK, et al.. Robbins and Cotran Pathologic Basis of Disease. 9th ed. Red Blood Cell and Bleeding Disorders, pp. 649-650. [2] Kumar V, Abbas AK, et al.. Robbins and Cotran Pathologic Basis of Disease. 9th ed. Diseases of Infancy and Childhood, pp. 470-472. [3] Kumar V, Abbas AK, et al.. Robbins and Cotran Pathologic Basis of Disease. 9th ed. Red Blood Cell and Bleeding Disorders, pp. 648-649.
Explanation: ### Explanation **Correct Answer: C. Aplastic Anemia** The patient presents with **pancytopenia**, which is defined as a simultaneous decrease in all three peripheral blood cell lines: * **Anemia:** Hb 6 g/dL (Normal: 13–15 g/dL) * **Leukopenia:** TLC 3,500/mm³ (Normal: 4,000–11,000/mm³) * **Thrombocytopenia:** Platelets 50,000/mm³ (Normal: 1.5–4.5 lakh/mm³) **Aplastic anemia** is a primary bone marrow failure syndrome characterized by a hypocellular marrow where hematopoietic stem cells are replaced by fat [2]. It is the most classic cause of "pure" pancytopenia without hepatosplenomegaly [2]. --- ### Why the other options are incorrect: * **Leukemia:** While acute leukemia can cause pancytopenia due to marrow replacement, it typically presents with a **high TLC** (due to circulating blasts) or at least the presence of immature cells [1]. Clinical features like lymphadenopathy or splenomegaly are usually present, which are absent in aplastic anemia. * **Multiple Myeloma:** This is a plasma cell dyscrasia. While it can cause anemia and occasionally leukopenia in advanced stages (marrow infiltration), the hallmark is a **reversal of the A:G ratio**, lytic bone lesions, and M-spike on electrophoresis, rather than isolated acute pancytopenia [3]. * **Megaloblastic Anemia:** This can cause pancytopenia; however, it is characterized by **macro-ovalocytes** and **hypersegmented neutrophils**. While a possible differential, Aplastic Anemia is the more "textbook" answer for a baseline pancytopenia question unless MCV or smear findings are provided. --- ### NEET-PG High-Yield Pearls: * **Gold Standard Diagnosis:** Bone marrow biopsy showing **hypocellularity** (fat space >75%) [2]. * **Most Common Cause:** Idiopathic (T-cell mediated destruction of stem cells) [2]. * **Drug Triggers:** Chloramphenicol, Sulonamides, and Carbamazepine. * **Fanconi Anemia:** The most common inherited cause of aplastic anemia (look for short stature and absent radii). * **Treatment of Choice:** Bone marrow transplant (young patients) or Immunosuppressive therapy (Antithymocyte globulin + Cyclosporine) [2]. **References:** [1] Kumar V, Abbas AK, et al.. Robbins and Cotran Pathologic Basis of Disease. 9th ed. Diseases of White Blood Cells, Lymph Nodes, Spleen, and Thymus, pp. 621-622. [2] Kumar V, Abbas AK, et al.. Robbins and Cotran Pathologic Basis of Disease. 9th ed. Red Blood Cell and Bleeding Disorders, pp. 662-663. [3] Cross SS. Underwood's Pathology: A Clinical Approach. 6th ed. Common Clinical Problems From Blood And Bone Marrow Disease, pp. 617-618.
Explanation: Explanation: Follicular Lymphoma (FL) is a B-cell neoplasm characterized by the translocation t(14;18)(q32;q21) [1, 2]. This translocation moves the BCL-2 gene from chromosome 18 to the immunoglobulin heavy chain (IgH) locus on chromosome 14 [1]. 1. Why Bcl-2 is correct: Under normal physiological conditions, germinal center B-cells are Bcl-2 negative to allow for apoptosis of cells that fail selection. In FL, the t(14;18) translocation leads to the overexpression of Bcl-2, an anti-apoptotic protein [1, 2]. This prevents programmed cell death, leading to the accumulation of neoplastic B-cells [2]. Immunohistochemistry (IHC) showing Bcl-2 positivity within the follicles is diagnostic, as it distinguishes FL from reactive follicular hyperplasia (where follicles are Bcl-2 negative) [1]. 2. Why other options are incorrect: * Abl: Associated with the t(9;22) Philadelphia chromosome, seen in Chronic Myeloid Leukemia (CML) and some cases of ALL. * Bax: A pro-apoptotic member of the Bcl-2 family. Overexpression of Bax would promote cell death, the opposite of what occurs in lymphoma. * Myc: Associated with the t(8;14) translocation, which is the hallmark of Burkitt Lymphoma, leading to rapid cellular proliferation. High-Yield Pearls for NEET-PG: * Morphology: Characterized by centrocytes (cleaved cells) and centroblasts [2]. * IHC Profile: CD19+, CD20+, CD10+, Bcl-2+, and Bcl-6+. Notably, it is CD5 negative (distinguishing it from CLL/SLL and Mantle Cell Lymphoma). * Clinical Course: Indolent (painless lymphadenopathy) but can transform into Diffuse Large B-cell Lymphoma (Richter-like transformation). **References:** [1] Kumar V, Abbas AK, et al.. Robbins and Cotran Pathologic Basis of Disease. 9th ed. Diseases of White Blood Cells, Lymph Nodes, Spleen, and Thymus, pp. 602-604. [2] Cross SS. Underwood's Pathology: A Clinical Approach. 6th ed. Common Clinical Problems From Diseases Of The Urinary And Male Genital Tracts, pp. 561-562.
Explanation: **Explanation:** **Hemoglobin E (HbE)** is a structural hemoglobin variant caused by a point mutation in the $\beta$-globin chain (substitution of glutamic acid by lysine at position 26). It is the most common hemoglobin variant in Southeast Asia and is highly prevalent in the **Eastern and North-Eastern regions of India**, particularly in **Bengal**, Assam, and Odisha. * **Bengal (Correct):** The gene frequency of HbE in West Bengal ranges from 3% to 10%. It is often found in the form of **E-$\beta$ Thalassemia**, which clinically presents as a condition similar to Thalassemia Intermedia or Major. * **Punjab (Incorrect):** This region is more commonly associated with a high prevalence of **$\beta$-Thalassemia trait** and **HbS (Sickle cell)** in specific tribal pockets, but not HbE. * **Kerala (Incorrect):** While hemoglobinopathies exist in South India, the prevalence of HbE is negligible compared to the Eastern belt. * **Maharashtra (Incorrect):** This region (specifically the Vidarbha belt) is a high-prevalence zone for **Sickle Cell Disease (HbS)** and $\beta$-Thalassemia, but HbE is not the dominant variant here. **High-Yield NEET-PG Pearls:** 1. **Electrophoresis:** On alkaline electrophoresis (pH 8.6), HbE migrates with **HbA2 and HbC** (Mnemonic: **A2CE** stay together). 2. **Morphology:** Peripheral smear typically shows **Target cells** and microcytic hypochromic indices. 3. **Protection:** Like HbS and Thalassemia, HbE is thought to provide a selective survival advantage against *Plasmodium falciparum* malaria. 4. **HbE-Thalassemia:** This is the most common cause of transfusion-dependent thalassemia in many parts of Eastern India.
Explanation: ### Explanation **Agranulocytosis** is a clinical syndrome characterized by a severe and dangerous reduction in the number of circulating granulocytes, specifically **neutrophils**. #### 1. Why Option A is Correct The term "agranulocytosis" is technically a misnomer; while it implies a total lack of all granulocytes (neutrophils, eosinophils, and basophils), it is clinically defined as a **profound reduction in the Absolute Neutrophil Count (ANC)**, typically **<500 cells/µL** (and often <200 cells/µL). Since neutrophils constitute the vast majority of the total white blood cell count, their depletion is the most striking and clinically significant finding, leading to severe susceptibility to bacterial and fungal infections. [1] #### 2. Why Other Options are Incorrect * **Option B & D:** Increased eosinophils or monocytes are not characteristic of agranulocytosis. In some cases of recovery from drug-induced agranulocytosis, a transient "monocytosis" may be seen as the bone marrow begins to regenerate, but it is not the defining feature. [2] * **Option C:** While basophils may be decreased, they are already present in very low numbers in normal blood. Therefore, their decrease is not "striking" or diagnostic compared to the massive drop in neutrophils. #### 3. NEET-PG High-Yield Pearls * **Most Common Cause:** Drug-induced (e.g., **Clozapine**, Antithyroid drugs like Methimazole/PTU, Phenylbutazone, and Sulfonamides). [1] * **Clinical Presentation:** Patients typically present with high-grade fever, chills, and **necrotizing ulcerations** of the oral cavity (agranulocytic angina) or pharynx. [1] * **Morphology:** The bone marrow may show a "maturation arrest" at the promyelocyte stage or a total absence of granulocytic precursors, depending on the etiology. [1] * **Treatment:** Immediate withdrawal of the offending drug and administration of **G-CSF** (Granulocyte Colony-Stimulating Factor). **References:** [1] Kumar V, Abbas AK, et al.. Robbins and Cotran Pathologic Basis of Disease. 9th ed. The Heart, pp. 590-592. [2] Cross SS. Underwood's Pathology: A Clinical Approach. 6th ed. Common Clinical Problems From Blood And Bone Marrow Disease, pp. 580-581.
Explanation: **Explanation:** The correct answer is **Turner Syndrome (45, XO)**. Unlike the other options, Turner syndrome is a sex chromosome aneuploidy characterized by the absence of one X chromosome. It is primarily associated with congenital heart defects (coarctation of the aorta), short stature, and gonadal dysgenesis, but it does **not** carry an increased risk for leukemia. **Why the other options are incorrect:** * **Bloom Syndrome:** This is an autosomal recessive disorder caused by a mutation in the *BLM* gene (DNA helicase). It leads to chromosomal instability and "sister chromatid exchanges," significantly increasing the risk of various malignancies, particularly **Acute Myeloid Leukemia (AML)**. * **Down Syndrome (Trisomy 21):** This is the most high-yield association. Children with Down syndrome have a 10–20 fold increased risk of leukemia [1]. Specifically, they are prone to **Acute Megakaryoblastic Leukemia (AML-M7)** before age 3 and **Acute Lymphoblastic Leukemia (ALL)** after age 3. * **Ataxia Telangiectasia:** This is a DNA repair defect (ATM gene mutation). Patients have increased sensitivity to ionizing radiation and chromosomal instability, leading to a high predisposition for **T-cell ALL** and lymphomas. **NEET-PG High-Yield Pearls:** * **DNA Repair Defects:** Bloom syndrome, Fanconi anemia, and Ataxia telangiectasia are all "Chromosomal Breakage Syndromes" that predispose to leukemia. * **Down Syndrome Mnemonic:** Remember **"7 before 3, ALL after 3"** (M7 subtype of AML is common in those under 3 years old). * **Neurofibromatosis Type 1:** Also associated with an increased risk of Juvenile Myelomonocytic Leukemia (JMML). **References:** [1] Kumar V, Abbas AK, et al.. Robbins and Cotran Pathologic Basis of Disease. 9th ed. Genetic Disorders, pp. 170-172.
Explanation: **Explanation:** Hemophilia A (Factor VIII deficiency) and Hemophilia B (Factor IX deficiency) are X-linked recessive disorders characterized by defects in the **intrinsic pathway** of the coagulation cascade [2], [4]. **Why PTT is the correct answer:** The **Activated Partial Thromboplastin Time (aPTT/PTT)** measures the integrity of the intrinsic and common pathways (Factors XII, XI, IX, VIII, X, V, II, and I) [2]. Since Hemophilia involves deficiencies in Factors VIII or IX, the PTT will be significantly **prolonged**. It is the most sensitive screening tool for these specific factor deficiencies. **Analysis of incorrect options:** * **Prothrombin Time (PT):** This tests the **extrinsic pathway** (Factor VII) and the common pathway [2]. PT remains **normal** in Hemophilia because Factor VII levels are unaffected. * **Bleeding Time (BT):** This measures **platelet function** and primary hemostasis (platelet plug formation). In Hemophilia, platelet count and function are normal; therefore, BT is **normal**. * **Clotting Time (CT):** While CT can be prolonged in severe Hemophilia [3], it is an **insensitive and obsolete** test. It only becomes abnormal when factor levels are extremely low (<1%), making it a poor screening tool compared to PTT. **NEET-PG High-Yield Pearls:** 1. **Mixing Study:** If PTT is prolonged, a mixing study (1:1 with normal plasma) is performed. If PTT corrects, it indicates a **factor deficiency** (Hemophilia); if it fails to correct, it suggests a **coagulation inhibitor**. 2. **Confirmatory Test:** The definitive diagnosis of Hemophilia is made via a **Specific Factor Assay**. 3. **vWD vs. Hemophilia:** In von Willebrand Disease, both BT and PTT may be prolonged (as vWF stabilizes Factor VIII) [1], whereas in Hemophilia, only PTT is prolonged. **References:** [1] Kumar V, Abbas AK, et al.. Robbins and Cotran Pathologic Basis of Disease. 9th ed. Red Blood Cell and Bleeding Disorders, pp. 669-670. [2] Kumar V, Abbas AK, et al.. Robbins and Cotran Pathologic Basis of Disease. 9th ed. Hemodynamic Disorders, Thromboembolic Disease, and Shock, pp. 128-130. [3] Kumar V, Abbas AK, et al.. Robbins and Cotran Pathologic Basis of Disease. 9th ed. Red Blood Cell and Bleeding Disorders, pp. 670-671. [4] Cross SS. Underwood's Pathology: A Clinical Approach. 6th ed. Common Clinical Problems From Blood And Bone Marrow Disease, pp. 622-623.
Anemias: Classification and Approach
Practice Questions
Hemolytic Anemias
Practice Questions
Myeloproliferative Neoplasms
Practice Questions
Myelodysplastic Syndromes
Practice Questions
Acute Leukemias
Practice Questions
Chronic Leukemias
Practice Questions
Lymphomas and Lymphoid Neoplasms
Practice Questions
Plasma Cell Disorders
Practice Questions
Bleeding Disorders
Practice Questions
Thrombotic Disorders
Practice Questions
Get full access to all questions, explanations, and performance tracking.
Start For Free